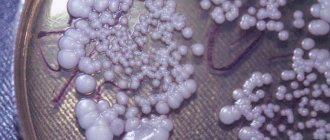

“Akklimashka” or “gornyashka”... A person who has nothing to do with climbing mountains, hearing these words, is unlikely to guess that they mean a dangerous condition, the complications of which can be pulmonary and cerebral edema. In the professional slang of mountaineers, this is called mountain sickness. Its symptoms develop in two out of ten people when climbing to a height of over 2 thousand meters. Let's find out what kind of disease this is, how it manifests itself, whether you can protect yourself from this danger and what to do when its signs appear.
What is altitude sickness?
Mountain sickness is a type of high-altitude hypoxia; this condition occurs due to a lack of oxygen when climbing mountains. Most of us live at low altitudes relative to sea level. When rising to a height of more than 2 thousand meters, unpredictable processes can occur in the body.
The higher the altitude, the lower the atmospheric pressure and the partial pressure of oxygen in the air. Because of this, less oxygen enters the blood, and the entire body as a whole feels a lack of it. But cells need oxygen, every second. When climbing a mountain, with every hundred meters traveled, less and less oxygen is supplied, the body experiences hypoxia - breathing becomes more frequent, sleep is disturbed, and a loss of strength is felt. Usually after a day the body gets used to the new conditions and the condition stabilizes. But adaptation takes time. By the way, at an altitude of just over 5 thousand meters in the Andes there are even settlements of mountain peoples. They are accustomed to such conditions, have adapted to life in them and feel great.
Pathogenesis
The pathogenesis of mountain sickness first manifests itself as cyanosis (blue discoloration of the skin, lips and nails), and after a few weeks the human body begins to produce a large number of red blood cells in order to transport oxygen to the tissues.
In addition to these symptoms of the disease, complications may also occur, including:
- swelling of the hands, feet and face;
- retinal hemorrhage;
- pulmonary edema;
- cerebral edema.
High-altitude swelling of the face, hands and feet occurs quite often among travelers, skiers and climbers. The main cause of this form of mountain sickness is the redistribution of salts in the body at high altitudes.
High-altitude retinal hemorrhage sometimes occurs after rising to even a small height. This condition is extremely rarely accompanied by other symptoms and disappears on its own quite quickly. Rarely, blurred vision may occur in one or both eyes, which quickly returns to normal after descending.
Pulmonary edema (fluid builds up in the lungs) is a more dangerous condition that can develop as a result of acute altitude sickness. The likelihood of its occurrence is higher in men than in women. In addition, in the presence of infection (for example, ARVI), the likelihood of this complication increases several times. This condition usually develops 1–4 days after rising.
The pathogenesis of mountain sickness is often associated with pulmonary edema, which is manifested by severe shortness of breath, a slight increase in body temperature and cough. The cough is at first quite dry and irritating, but then it becomes moist with frothy sputum, sometimes even bloody. This complication progresses rapidly and can lead to a life-threatening condition within a few hours.
Cerebral edema due to altitude sickness is the most dangerous form of complication. It develops 1–4 days after rising to a high altitude. Very often it is preceded by acute mountain sickness or pulmonary edema. Brain edema in this case is caused by the accumulation of fluid in the brain tissue. People prone to altitude sickness should pay attention to such precursors of complications as severe headaches and difficulty walking, which are accompanied by impaired coordination of fine motor skills of the hands.
In addition, the pathogenesis of mountain sickness and high-altitude cerebral edema sometimes even involves hallucinations, impaired perception and thinking. These manifestations resemble a state of alcohol intoxication.
Cerebral edema is extremely dangerous and can cause death, therefore, with this complication, the victim must be taken down as quickly as possible.
Another form of the disease is subacute mountain sickness. This unusual condition is sometimes observed in children under one year of age who were born at moderate altitudes, as well as in people who spend long periods of time at altitudes greater than 6,000 m above sea level. This condition is caused by heart failure, which causes large amounts of fluid to accumulate in the legs, abdomen and lungs. In order to save a person's life, he should be brought down, after which the symptoms will disappear.
Chronic mountain sickness is another type of disease that develops gradually over several months in people who constantly live at high altitudes. Manifestations of the disease include drowsiness, shortness of breath, pain in different parts of the body. The disease is dangerous because blood clots form in the vessels of the lungs and legs, and as a result, heart failure may develop. The disease is caused by the fact that the human body compensates for the lack of oxygen and produces a lot of red blood cells. Because of this, the person’s condition deteriorates sharply, and he must be urgently taken down.
Factors contributing to the development of mountain sickness
In addition to the lack of oxygen, factors such as:
- physical fatigue;
- lack of proper rest;
- hypothermia;
- poor diet;
- drinking alcohol and caffeinated drinks;
- overweight;
- presence of cardiovascular diseases;
- sudden change in weather conditions.
Not all people are equally susceptible to this disease. It is believed that women can more easily tolerate a lack of oxygen. Age, general health, and level of physical fitness are also important. The development of altitude sickness is directly related to the speed of ascent and the time spent at altitude.
Mechanisms of edema
With further elevation, hypoxia increases, since the compensatory functions of the body no longer provide sufficient compensation. The lack of oxygen in the surrounding air leads to a decrease in the partial pressure of oxygen in the lungs and to a decrease in the saturation of arterial blood with oxygen, resulting in pulmonary and cerebral edema.
There is a point of view that the main clinical manifestations of acute mountain sickness are based on increasing cerebral edema.
In humans, the most sensitive and vulnerable to hypoxia are the tissues of the brain and the tissue of the pulmonary alveoli, since the latter receive oxygen directly from the air. It is the insufficient supply of oxygen to these tissues that causes the development of edematous processes in them. The main sources of pulmonary and cerebral edema:
- increased pressure in blood vessels and capillaries due to their spasm, water retention in the body and stagnation of blood in the venous system;
- increasing the permeability of the capillary wall, which leads to the release of liquid plasma components into the intercellular space;
- increased permeability of the cell membrane - hypoxia disrupts the selective permeability of cell membranes, as a result of which the concentrations of ions outside and inside the cell begin to equalize: that is, the cell loses K+ ions and is overloaded with Na+, Ca2+ ions;
- decrease in oncotic pressure of blood plasma - equalization of sodium concentration (0.9%) in the body leads to hydration of cells and thickening of the blood.
Other mechanisms are added to the hypoxic mechanism:
- lack of potassium in the myocardium leads to arrhythmia, to a weakening of the pumping function of the heart, which manifests itself in stagnation of venous blood in the pulmonary (with pulmonary edema) or large (with cerebral edema) circulation;
- increase in body temperature (fever) - in response to hypothermia, swelling, exacerbation of chronic inflammatory processes and other things, body temperature rises. This immune stereotype, “useful” under normal conditions, in conditions of lack of oxygen further aggravates hypoxia, since with an increase in body temperature the need for oxygen increases. It has been established that at 38°C the need for oxygen doubles, and at 39.5°C it increases 4 times;
- due to increased permeability of the walls of the pulmonary capillaries and alveoli, foreign substances (protein masses, blood elements and microorganisms) penetrate into the alveoli of the lungs;
- cold effect - cold air acts in three ways:
- in severe frost and wind, cold air has to be inhaled in small portions that burn the lungs and throat, which increases hypoxia;
- in the cold, hypoxic edema is also accompanied by edema from hypothermia. In supercooled tissues, the permeability of cell membranes is also impaired (therefore, frozen tissues swell);
- Because of the cold, chronic inflammatory diseases are exacerbated, which accelerate and aggravate pulmonary edema.
Therefore, at low temperatures, pulmonary or cerebral edema occurs more quickly - at high altitudes and in extreme cold, this period can be only 8-12 hours instead of the usual 24 hours.
Cerebral edema is an excessive accumulation of water in the brain tissue, and the source of water is mainly blood flowing through microvessels and cerebral capillaries.
Pulmonary edema is the accumulation of light blood plasma in the tissues of the lungs, and then in the lumens of the alveoli: when inhaling, the plasma filling the lumens foams, sharply reducing the useful volume of the lungs.
As a rule, cerebral edema and pulmonary edema develop at night (the peak of the crisis most often occurs at 4 a.m.), which is due to:
- increased venous return to the upper half of the body when moving from a vertical to a horizontal position;
- a decrease in the activity of the central nervous system, which, superimposed on respiratory acidosis, leads to a weakening of respiratory function (see above);
- increased tone of the vagus nerve, causing bronchospasm.
What can be concluded from:
- the horizontal position of the sick person is unacceptable at any time of the day;
- every hour of night time should be used not for sleep (which is not available anyway), but for going down; The patient's condition always worsens noticeably by morning.
The cause of death with cerebral edema is compression of the swollen cerebral cortex by the cranial vault, wedging of the cerebellum into the spinal cord trunk. The cause of death in pulmonary edema is massive foaming, causing asphyxia of the respiratory tract.
The reason for the transience of death is that they develop according to the principle of a vicious circle, when subsequent stages aggravate the original cause, and the original cause aggravates the consequences (for example, compression of the veins of the brain leads to more severe edema and vice versa).
How does altitude sickness manifest?
Signs of altitude sickness in some people begin to appear already when crossing a mark above 2 thousand meters (for example, while climbing Mount Fisht as part of an active tour to Adygea). First, mental retardation, weakness, and drowsiness appear. Lack of appetite, flatulence and indigestion may occur.
At an altitude above 4 thousand meters, some people may experience behavior similar to that of alcohol intoxication: talkativeness increases, gesticulation appears, sudden laughter appears, the feeling of fear disappears and the instinct of self-preservation becomes dulled. For others, on the contrary, the consciousness becomes clouded, the person feels exhausted, may answer questions incoherently and inappropriately, and complain of nausea and dizziness.
With a sharp climb to altitude, all of the above symptoms of altitude sickness may be supplemented by a severe headache localized in the temples, nosebleeds, blue lips, fever and even hallucinations.
Forecast
Forecast of acute and subacute forms of G. b. with timely treatment and professional measures, it is usually favorable. In case of untimely treatment, acute G. b. severe cases (especially acute high-altitude pulmonary edema) can lead to death from hypoxic coma. With chronic G. b. the prognosis depends on the individual characteristics of the course; in some patients, the ability to work progressively decreases; death usually occurs as a result of hypoxic coma or as a result of cardiac, predominantly right ventricular failure. The general condition and prognosis improve with the evacuation of patients chronically. G. b. to the lowlands.
What to do if symptoms of mountain sickness appear?
There is no cure for altitude sickness as such. All medications taken are aimed at eliminating symptoms. Mild symptoms of altitude sickness do not require medication and can affect almost anyone who goes to high altitudes. If problems with the gastrointestinal tract occur, you can drink Imodium or activated carbon. The main thing is to monitor your water balance and constantly replenish it.
If a headache occurs, you need to take a pain reliever, for example, Ibuprofen or Citramon. High fever is brought down with Paracetamol or other antipyretics. For vomiting and nausea, you can take an antiemetic drug - Cerucal solution. It is important to provide the patient with peace and let him rest.
For more serious symptoms, only going down can help. It happens that in severe cases the patient requires hospitalization, but most often the symptoms go away on their own a few hours after returning to the usual altitude. Regardless of the stage of the “miner”, after descent the state of health improves.
Diagnosis and treatment
Diagnosis of mountain sickness is carried out solely on the basis of clinical manifestations. The first symptoms such as headache, nausea, loss of appetite, vomiting, shortness of breath, weakness, sleep disturbance and dizziness may indicate the onset of the disease. These manifestations appear within 6–12 hours after rising and disappear on days 2–3, if you do not rise higher, as the body adapts.
When symptoms of the disease appear, it is necessary to drink a lot of fluid to replenish its loss. In addition, for mild forms of the disease, you can take ibuprofen, and for more serious cases, drugs such as Dexamethasone and Acetazolamide, as well as their combination, are effective.
As for high-altitude cerebral edema, it is also treated with corticosteroids (for example, dexamethasone), but in severe cases the patient should be lowered. In any form of the disease, after descent the victim’s condition improves.
How to protect yourself from the “miner”?
The best prevention of altitude sickness is a gradual and leisurely ascent. An altitude of 2 thousand meters must be overcome in about 2 days, and in each subsequent day you must rise no more than 600 meters. In addition, when drawing up a plan for climbing a mountain, it is important to focus on the physical capabilities of the weakest member of the group.
Remember that one of the triggers for altitude sickness is dehydration. When getting up, you should try to drink more fluids and limit your salt intake. The diet should contain a sufficient amount of fast carbohydrates; their consumption reduces the likelihood of developing the disease. To minimize the likelihood of serious complications from altitude sickness, a climber must have an oxygen cylinder in his backpack.
Watch the video about altitude sickness if you want more information:
If you can’t wait to experience the manifestations of mining, sign up for a hike to Elbus (more details at the link) or a trip to Nepal.
Treatment
With moderate severity of acute (subacute) Mountain sickness, limit the amount of food taken and the consumption of foods that contribute to flatulence. Special breathing exercises are recommended, and, if necessary, oxygen inhalation. If symptoms G. b. do not regress in the next 3 days, further stay in the mountains is contraindicated. With G. b. severe cases, evacuation of patients to lowlands is absolutely necessary. In these cases, oxygen therapy is mandatory (see Oxygen therapy), cardiovascular drugs are prescribed according to indications, as well as B vitamins (especially riboflavin), rutin, ascorbic acid, glucose, anabolic hormones; At night, medications from the group of minor tranquilizers are recommended.
Treatment of acute high-altitude pulmonary edema begins with immediate oxygen therapy and warming of patients; “defoamers” are used, secretions are suctioned from the trachea and bronchi; fast-acting diuretics, ascorbic acid, calcium chloride are administered intravenously, after 15-20 minutes - corglicon or strophanthin; Rutin and glucocorticoids are also prescribed. All patients with acute high-altitude pulmonary edema are subject to emergency evacuation to areas located below 2000 m.
Treatment chronic. G. b. with pulmonary hypertension has not been sufficiently developed. Symptomatic therapy is mainly used. All indigenous highlanders with decompensated stages of chronic. G. b. must be transferred to permanent residence in the lowlands.
What to do?
If you think you have altitude sickness
and the symptoms characteristic of this disease, then doctors can help you: an otolaryngologist, a therapist.
Diseases with similar symptoms
Alport syndrome (hereditary nephritis) (overlapping symptoms: 9 of 20)
Alport syndrome or hereditary nephritis is a kidney disease that runs in families. In other words, the disease affects only those who have a genetic predisposition. Men are most susceptible to the disease, but the disease also occurs in women. The first symptoms appear in children between 3 and 8 years of age. The disease itself may be asymptomatic. Most often it is diagnosed during a routine examination or during the diagnosis of another underlying disease.
... Coarctation of the aorta (overlapping symptoms: 9 out of 20)
Coarctation of the aorta is a congenital form of narrowing of the lumen of the aorta in one of its segments, localized in the isthmus zone, i.e., in the area where the arch transitions to the descending region. Pathology is observed several times less often in the ascending and abdominal sections.
... Vertebrobasilar insufficiency (overlapping symptoms: 9 out of 20)
Vertebro-basilar insufficiency (vertebrobasilar syndrome) is a disturbance in the functioning of the brain due to poor blood supply in the vertebral and basilar arteries. The last one is the main one in the brain. Due to possible vasoconstriction, the brain does not receive enough oxygen, which leads to disorders of the central nervous system.
… Neurasthenia (overlapping symptoms: 8 out of 20)
Stress in the life of a modern person is a fairly common phenomenon, and sometimes the human psyche cannot cope with such a load. Due to nervous exhaustion, a disease such as neurasthenia can occur. Most often, this disease occurs in young men and women, but in practice it cannot be said that any social or age group is completely free from the risk of developing neurasthenia. Sometimes neurasthenia occurs in children, as well as sexual neurasthenia, which is characterized by the presence of sexual disorders.
... Brain cancer (overlapping symptoms: 8 out of 20)
Brain cancer is a disease, as a result of the progression of which a malignant tumor is formed in the brain, growing in its tissue. The pathology is very dangerous and in most clinical situations ends in death. But the patient’s life can be significantly extended if the first signs of the disease are identified in a timely manner and go to a medical facility for comprehensive treatment.
Source
Did you like the article? Share with friends on social networks:
Treatment of the disease
The tactics of therapeutic measures will depend on the current condition of the patient. If there is a compensation stage, and the nature of the pathological process is not severe, then hospitalization is not necessary - medical measures are taken to improve the patient’s condition.
First aid for mountain sickness.
First aid consists of the following activities:
- provide the victim with sufficient oxygen;
- give water;
- give pills to prevent brain swelling;
- transport the victim to a medical facility as soon as possible.
The pharmacological part of the treatment is based on the following drugs:
- Acetazolamide;
- Dexamethasone - to prevent cerebral edema;
- antispasmodics;
- pain reliever;
- to stabilize blood pressure;
- antianginal;
- nootropic;
- neuroleptics;
- antiemetics;
- astringents;
- anticoagulants;
- sedatives;
- antidepressants;
- sleeping pills.
Some medications are administered to the patient intravenously or intramuscularly. Any medications should be taken only as prescribed by a doctor. It is strongly not recommended to change the dosage or dosage regimen on your own.
Additionally, a course of multivitamin preparations and special nutrition are mandatory. If the patient's condition is extremely severe, then nutrients are administered to the patient orally.
A patient in this state needs to be provided with complete rest, both emotionally and physically. You also need to ensure that the victim drinks enough fluids per day.
The situation becomes more complicated if the patient has other diseases. Then the course of therapeutic measures will be simultaneously aimed at stabilizing the patient’s condition and eliminating complications that arose against the background of the underlying disease.
Altitude sickness while hiking and climbing - how to prevent it?
In order to weaken the effect of hypoxia, several effective methods have been developed, among which preparation for climbing, acclimatization, and proper nutrition deserve special attention.
Do you need to prepare for the climb?
To avoid mountain sickness while hiking and climbing, careful preparation is needed. During the two to three weeks preceding the ascent, training should begin. Adaptation to altitude by conquering low altitudes, spending a short time at these altitudes and quickly descending, as well as repeated alternation of ascents and descents, showed good effectiveness. Long-term acclimatization training accustoms human organs and tissues to work in conditions of oxygen deficiency.
Why is acclimatization needed?
Mountain sickness during mountain hiking and climbing, affecting the climber’s brain, deprives him of the ability to think critically about himself. When mild hypoxic euphoria sets in, everything seems accessible to a person. Tourists often try to organize competitions in rapid ascent. Such actions are extremely dangerous because they instantly disrupt adaptive mechanisms. As a result of rapid ascent, there is a high probability of hypoxic depression of consciousness, depression, and cardiovascular failure. On the contrary, proper acclimatization has a positive effect on the body’s adaptation to oxygen deficiency. With properly planned adaptation to mountain hiking, the body rearranges the order of redox processes and changes the composition of the blood, which allows it to better absorb oxygen and spend energy more economically.
What is the best method for adapting to altitude?
It is very important not to take a quick start in the first stages of trekking in the mountains. A good result was shown by the “run ahead” tactic, when the group stops for the night at an altitude that is lower than the highest point reached during the day. In Western Europe this method is called the "saw tooth" method. Despite the fact that “stepped” acclimatization requires a long period of time, it is the most effective and reliable method that makes it easier for the body to adapt to being at altitude. If a climber quickly rises from sea level to the top of Everest, he will die. However, there are already known cases when people conquered the highest peak without additional oxygen, spending a sufficient amount of time on the ascent - about 90 days.
The essence of the “saw teeth” method is to perform cycles: every day, rise and rest as high as possible, and then descend and spend the night as low as possible. For example, having gained 1000 m in a day, you should spend the night 400 m lower. With each subsequent ascent, the group reaches greater heights and reliably consolidates the experience of the previous day. It is very important to get a good rest at night. At this time, at altitude, a person is most vulnerable: he loses mobilization from the nervous system and tone, which is maintained during wakefulness by volitional efforts. At the same time, control of his condition by other participants in the ascent ceases. It is at night that deaths occur among those whose bodies are exposed to hypoxia. At the same time, a properly organized overnight stay at altitude makes it possible to adapt to this altitude to the greatest extent.
When choosing your actions, you should be guided by your heart rate - this is a pretty good indicator. The evening pulse of a tourist can be high and, in mild forms of mountain sickness, exceed 100 beats per minute. However, the morning contraction rate should drop to 80-90 beats per minute. If a person claims that his morning heart rate exceeds 105 beats per minute, then the group leader must escort him down, since he has not mastered the altitude during the night. Further ascent at such a morning pulse often leads to severe mountain sickness. At the same time, the group is delayed due to the fact that it has to lower the victim from an even greater height.
During the day's marches the group must move at the same pace. So that breathing is calm, uniform and does not get confused. Nepalese guides recommend moving in small steps at the speed of a yak - slowly. You can't do fast runs in the mountains, it's dangerous! At the same time, there is no need to be lazy during acclimatization. Continuous movement and moderate physical activity maintains blood circulation and makes it easier to cope with altitude sickness.
The altitude at which acclimatization starts is of great importance. If the group initially walks quickly and only at around 4000 m begins to move according to the rules of acclimatization, this can lead to wear and tear on the body and poor adaptation to high altitudes. It is not recommended to skip the acclimatization stage at an altitude of 3200-3500 m.
When trekking in the mountains, medical self-control and control over your condition is very important. Participants must periodically measure their pulse, blood pressure, and blood oxygen levels using a pulse oximeter.
At what altitude does altitude sickness occur when hiking and climbing?
Everyone who is planning to go on a high-altitude trek to the base camp of Everest or climb Elbrus thinks about at what altitude the intoxicating “miner” can catch him.
The first attempts to explain the painful sensations of a person in the mountains were made by the French physiologist Paul Ber, who published his monograph in 1875, in which he described the influence of barometric air pressure on the state of the body. Since then, scientists from different countries have been able to substantiate the reasons why altitude sickness occurs during mountain hiking and climbing. Moreover, they classified altitude levels according to the degree of comfort for a healthy person.
According to their findings, mountain zones can be divided according to the following scheme:
- up to 1000 m – low mountain zone, where the trekker does not lack oxygen even during intense work;
- 1000 - 3000 m is a mid-mountain zone, which is characterized by hidden hypoxia - the lack of oxygen there is felt only during intense muscular activity, and under conditions of moderate physical activity the human body easily compensates for oxygen deficiency;
- from 3000 – a high-altitude zone where the human body can undergo changes caused by oxygen starvation.
The highland zone has its own division and is divided into the following zones:
- “full acclimatization” - from 3000 to 5000 m, where, thanks to the mobilization of all compensatory reactions, the body copes with hypoxia, but for this it will require some time for acclimatization;
- “incomplete acclimatization” – from 5000 to 6000 m, where the human body cannot fully counteract the development of hypoxia; with a long stay in this zone, he develops fatigue, loses weight, and muscle tissue atrophies;
- “partial adaptation” - from 6000 to 8000 m, where the body cannot provide the most important organs with the necessary amount of oxygen, therefore, within 6-7 days of staying at this altitude, their activity begins to be disrupted;
- lethal zone (death zone) - above 8000 m, where a person loses resistance to the effects of altitude; under such conditions, the body’s internal reserves are depleted within 2-3 days.
In 1925, the famous German physiologist N. Zuntz expressed interesting thoughts in his scientific work that in different geographical areas the same symptoms of mountain sickness appear at different altitudes. Subsequently, this opinion was confirmed by research. For example, when hiking in Kamchatka, altitude sickness appears already at an altitude of 1500 m, in the Alps - at 2500 m, in hiking in the Caucasus and hiking in Altai - at 3000 m. However, when hiking in the Tien Shan or hiking in the Fan Mountains in the Pamir -Alai you can climb to a height of 3500-4500 m without experiencing discomfort in your well-being. In Nepal, during a certain season, you can easily trek around Annapurna and conquer the Thorong-La pass at a height of 5416 m. Moreover, in different mountain regions, the increase in hypoxia with increasing altitude also occurs differently.
Although scientists are still continuing to research the causes and mechanisms of altitude sickness, it is already clear that it cannot be associated only with oxygen deficiency. During high-mountain trekking in Nepal or climbing Kazbek, a tourist spends a lot of energy adapting the body to physical activity, strong winds, increased solar radiation, and temperature changes. The most important factor influencing the development of mountain sickness is climatic conditions. For example, researchers have noticed that dry air, which is characteristic of a continental climate, is much easier to breathe than more humid air, and therefore mountain sickness manifests itself in such a climate at high altitudes. This is confirmed by the fact that in the Himalayas, with a sharply continental climate, a climber begins to experience pain due to a lack of oxygen only at high altitudes (4000-5000 m), while in Kamchatka, where a humid maritime climate prevails, hypoxia occurs already in the mid-mountain zone.
In the 30s of the 20th century, some scientists indicated a connection between mountain sickness and the height of the snow or firn line. They noticed that climbers most often begin to feel pain in their bodies when they reach areas where large areas are covered with snow and ice. For example, the average height of the firn line in different mountain regions has the following values: in Scandinavia - 1500 m, in the Alps - 2900 m, on the Main Caucasus Range - 3400 m, in Altai - 2900 m, in the Himalayas - 5000 m. Climatic factors influencing the manifestation of altitude sickness and the formation of the firn line have similarities - humidity, air temperature, intensity of solar radiation. It is likely that a sharp decrease in temperature and increased radiation as a result of reflection from snow are the catalysts that, together with hypoxia, lead to the rapid manifestation of mountain sickness.
Based on experimental data, maps of high mountain areas have now been developed, which contain information about the initial altitude of manifestation of mountain sickness. Acclimatization levels of hypoxia are usually indicated using isolines.